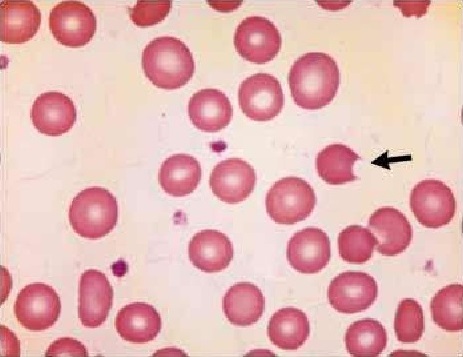

Déficit en glucose-6-phosphate déshydrogénase
Le Déficit en glucose-6-phosphate déshydrogénase est le déficit enzymatique le plus répandu dans le monde, se caractérisant par une destruction des globules rouges, en 2015 prêt de 400 million de personnes en était atteintes, se trouvant dans le chromosome X on le voit le plus souvent apparaitre chez le male.